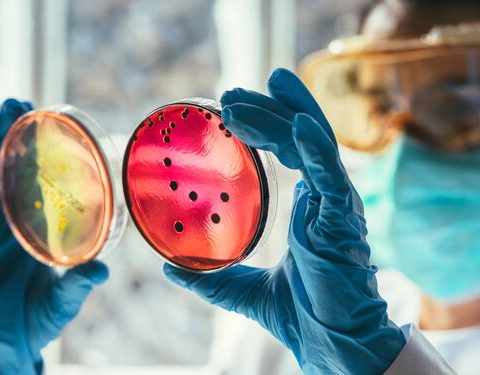

Armenta mete orden; hay siete detenidos por riña en la Feria
Siete personas fueron detenidas tras una riña registrada la noche del jueves 1 de mayo en inmediaciones de la Feria de Puebla 2025. El gobernador Alejandro Armenta confirmó los hechos y aseguró